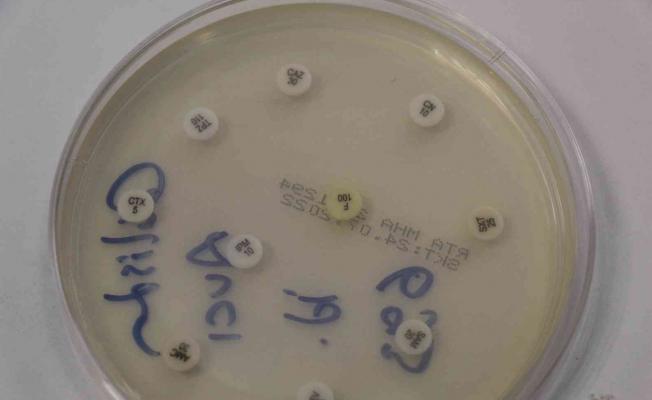

Yanlış kullanımda sağlığa zarar veren antibiyotiklerin dünyada ekonomiye maliyeti 100 trilyon dolar olarak ön görülüyor
Mardin Eğitim ve Araştırma Hastanesi Başhekim Yardımcısı Uzm. Dr. Sanmak, antibiyotiklerin ağrı kesici ve ateş düşürücü olmadığını ve yanlış …
Mardin Eğitim ve Araştırma Hastanesi Başhekim Yardımcısı Uzm. Dr. Sanmak, antibiyotiklerin ağrı kesici ve ateş düşürücü olmadığını ve yanlış kullanımında sağlıkta ciddi zararlara yol açabileceği uyarısında bulundu.
Başhekim Yardımcısı Uzm. Dr. Sanmak, şu ana kadar üretilen 100’den fazla antibiyotiğin pek çoğuna mikroplar direnç geliştirmiş durumda olduğunu, bu dirençli mikroplardan dolayı 2050 yılına kadar tüm dünyada 10 milyon kişinin öleceği tahmin edilmekte olduğunu öne sürdü.
“Güneydoğu Anadolu Bölgesi’nde gereksiz antibiyotik kullanımı yaygın”
Tüm dünyada ekonomiye ek maliyeti ise 100 trilyon dolar olacağı öngörülmekte olan antibiyotiklerin yanlış kullanımda insan sağlığına ciddi derecede zarar verdiğini ifade eden Sanmak, “Antibiyotikler sadece zararlı patojenler için ve sadece doktor reçetesi ile alınıp kullanılması gereken kimyasallar. Güneydoğu Anadolu Bölgesi’nde gereksiz antibiyotik kullanımı yaygın. Antibiyotik aslında insan hayatında o kadar eski değil. 1928 yılında ilk Alexander Fleming tarafından penisilinin bulunduğunu ve büyük bir buluştu olması hasebiyle Nobel Tıp ödülü aldı. Bundan sonra 100’e yakın antibiyotik keşfedildi. Ancak günümüze kadar birçok antibiyotik gereksiz kullanımından dolayı bakteriler direnç geliştirdi. Bölgemizde gereksiz kullanımdan dolayı direnç geliştirmesi yüksek. Hatta bazı hastalarımız aile hekimlerimize ısrarla antibiyotik kullanmak istediklerini söylüyor. Bu nedenden dolayı bölgemizde kullanımı yüksek” dedi.
“Antibiyotikler ateş düşürücü değildir”
Antibiyotiklerin ateş düşürücü ve ağrı kesici özellikleri bulunmadığını vurgulayan Sanmak, “Sadece bakterilerde etkilidir. Örneğin, çocuk nezle ise veya soğuk algınlığı ise hiçbir etkisi yoktur. Anneler sadece gereksiz olarak antibiyotik kullanmış oluyorlar. Çocuklarının bir sonraki hastalığında eğer bu bakteriyel bir hastalıksa daha zor bir tedavi edilmesine neden oluyorlar. Bundan dolayı kesinlikle gerekli muayene ve gerekli tetkikler yapılmadan antibiyotik kullanılmaması gerekiyor” diye konuştu.
Antibiyotiklerin Türkiye’de şu an sadece doktor reçetesi ile verildiğine değinen Sanmak, “Çocuğun veya yetişkin bireyin ilk ateşi çıktığında evde yarım kalmış antibiyotikler veya daha önceden bulunup kullanılmamış olan antibiyotikler kullanılabiliyor. Antibiyotiği ilk önce yarım bırakmamak gerekiyor. Tam olarak kullanmak gerekiyor. Antibiyotikler sadece doğru dozda, doğru zamanlarda ve doğru bakteriye doğru antibiyotik kullanıldığında yararlıdır. Bunların kullanımının bir uzman tavsiyesi ve reçetesi ile olması gerekiyor. Eğer böyle yapmazsak biz öncelikle kendimize zarar veriyoruz” şeklinde konuştu.
“Vücudumuzdaki yararlı bakterilerle yaşıyoruz, onlar bir organımız gibi”
Yararlı bakterilerin insan vücudunda kalp, karaciğer ve diğer organlar gibi gerekli olduğunun önemine değinen Sanmak, sözlerini şöyle sürdürdü:
“Yanlış kullanımda bağırsak floramızı bozuyoruz. Kendi vücudumuzda yararlı bakterilerde yaşıyoruz aslında. Yararlı bakteriler vücudumuzda karaciğer, akciğer gibi organımız sayılır. Bunlara zarar veriyoruz. Bizim nasıl kalbimiz için zararlı bir şey tüketmememiz gerekiyorsa antibiyotiğin de gereksiz kullanımı bu organlarımıza, yararlı bakterilerimize zarar vermektedir. Sonuçları nedir? Öncelikle kısa vadede bağırsak problemleri ve ishale neden olabiliyor. Uzun vadede astım, diyabet ve obezite gibi hastalıklara neden oluyor. Hatta bazı zamanlarda kansere bile neden olduğu iddia ediliyor. Bundan dolayı kullanmamız gerekiyor.”
Gereksiz antibiyotik kullanımı veya kullanılması gerektiğinde yararlı bakterileri korumak için yapılması gerekenlere değinen Sanmak, “Öncelikle bir denge var sistemimizde buna biz mikrobiyata diyoruz. Mikrobiyota insan ile bakteriler arasında bir dengedir. Bu dengeyi korumak için öncelikle gereksiz antibiyotikleri kullanmamamız gerekiyor. Fakat sonrasında eğer kullanırsak probiyotikli besinlerimiz var. Yoğurt gibi besinler kullanabiliriz. Bol yeşillikli besinler tüketerek bağırsak sistemlerimizi rahatlatabiliriz. Bu şekilde bu dengeyi koruyabiliriz. Burada yine de kritik nokta gereksiz antibiyotik kullanımı. Bu psikolojik bir etki olabiliyor. Örneğin insanlar kendini hasta hissettiğinde antibiyotik kullandıklarında kendilerini rahatlamış hissediyorlar. Bunun psikolojik etkisinden başka bir etkisi yok ne yazık ki. Kesinlikle bu antibiyotikleri bakteri enfeksiyonları dışında yararlı değil” ifadelerinde bulundu.